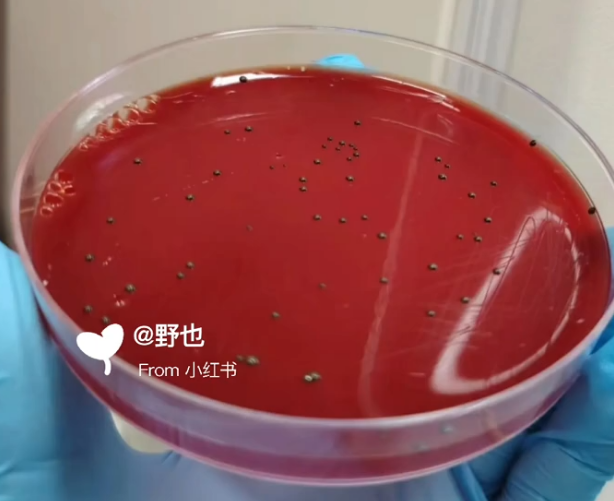
专注口腔微生物研究：迈睿可生物提供标准牙龈卟啉单胞菌菌种

新闻中心
最新企业动态和行业资讯
共找到 18 篇新闻
阅读全文
2 月,2 周前发布
成都迈睿可生物科技有限公司:专业幽门螺杆菌固体培养基,助力胃微生物研究
阅读全文
5 月,1 周前发布
成都迈睿可生物科技有限公司:专业RNA提取逆转录技术服务,赋能基因表达研究
阅读全文
5 月,2 周前发布
成都迈睿可生物科技有限公司:提供专业整体项目技术服务,助力科研项目高效实施
阅读全文
5 月,3 周前发布
守护细胞实验纯净:迈睿可生物推出专业支原体清除剂
阅读全文
5 月,4 周前发布
Caco-2细胞模型的技术服务
阅读全文
6 月,1 周前发布
高效科研!幽门螺杆菌快速尿酶检测试剂,迈睿可助力精准鉴定
阅读全文
6 月,2 周前发布
精准定量,省时省力:迈睿可生物提供专业qPCR代做服务
阅读全文
6 月,4 周前发布
专注口腔微生物研究:迈睿可生物提供标准牙龈卟啉单胞菌菌种
阅读全文
7 月前发布
第 1 页,共 2 页
下一页